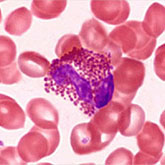
eosinophil

Histology is the study of the microanatomy of cells, tissues, and organs as seen through a microscope. It examines the correlation between structure and function.
Histology Guide teaches the visual art of recognizing the structure of cells and tissues and understanding how this is determined by their function. Rather than reproducing information found in a histology textbook, a user is shown how to apply this knowledge to interpret cells and tissues as viewed through a microscope.
Because of the high cost of purchasing (and maintaining) microscopes and preparing (or purchasing) slide collections, histology is often taught today without laboratories. A histology atlas is frequently used as a replacement. This is unfortunate because no matter how good the few images in a textbook or histology atlas are, they cannot replace the experience of viewing a specimen through a microscope.
Histology Guide solves this problem by recreating the look and feel of a microscope in an intuitive, browser-based interface.
An Aperio slide scanner was used to obtain a high-resolution image of each slide in its entirety. Large tissues are up to 34 GB for a single, uncompressed image of 150,000 x 75,000 pixels.
The contrast, color, and sharpness of each image were adjusted to at least maintain the appearance of the tissue as seen through a microscope. In many cases, these adjustments improved upon their visual appearance.
Unlike low-resolution images, users can interactively explore these large images by zooming-and-panning in real-time. A software-based virtual microscope (Zoomify HTML5 Enterprise) allows the examination of large and small structures in the same specimen.
This approach provides a more engaging learning experience and sense of scale, proportion and context that is not possible with a traditional histology textbook or atlas.
The Atlas of Human Histology: A Guide to Microscopic Structure of Cells, Tissues and Organs by Robert L. Sorenson and T. Clark Brelje provides a print version of the core slides from this website. Individual slides are presented as a series of images of increasing magnification to help convey a sense of scale and proportion. This atlas allows each student to have an easily accessible, printed summary of the essential slides from this website.
Histology Guide is intended to be used with - not replace - a good histology textbook.
Questions, comments or suggestions should be sent to tcbrelje@gmail.com